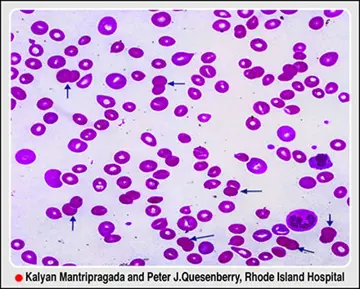

شماره ۱۰۳۱
هماتولوژی - صفحه 16
شماره ۱۰۳۱
شماره ۱۰۳۰
شماره ۱۰۳۰
شماره ۱۰۳۰
شماره ۱۰۲۹
شماره ۱۰۲۸
شماره ۱۰۲۷
شماره ۱۰۲۶
شماره ۱۰۲۵